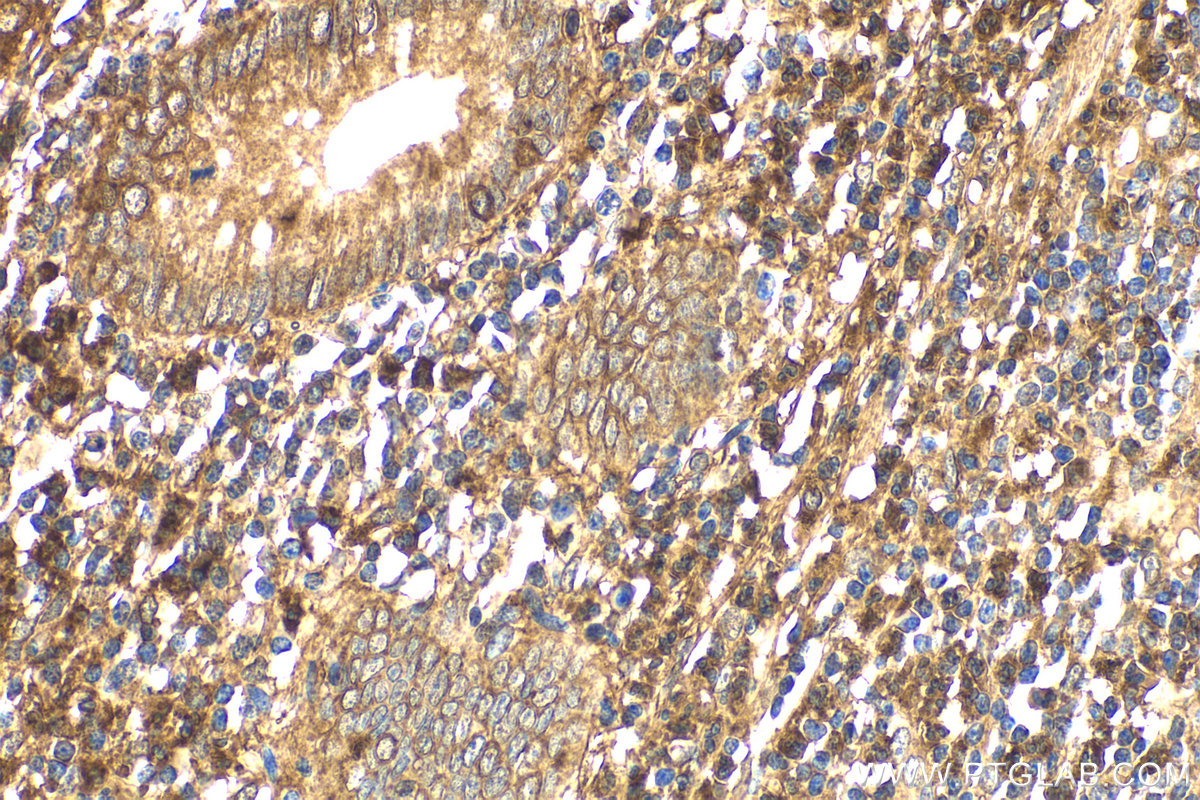

IHCeasy® FYN Ready-To-Use IHC Kit
FYN Ready-to-use reagent kit for IHC.
Reactivity
Human, Mouse, Rat
Sample Type
FFPE tissue
Cat no : KHC2164
Synonyms
Proto-oncogene c-Fyn, Proto oncogene Syn, Proto oncogene c Fyn, p59-Fyn, p59 Fyn
Validation Data Gallery
Product Information
KHC2164 is a ready-to-use IHC kit for staining of FYN. The kit provides all reagents, from antigen retrieval to cover slip mounting, that require little to no diluting or handling prior to use. Simply apply the reagents to your sample slide according to the protocol and you're steps away from obtaining high-quality IHC data.
| Product name | IHCeasy FYN Ready-To-Use IHC Kit |
| Sample type | FFPE tissue |
| Assay type | Immunohistochemistry |
| Primary antibody type | Mouse Monoclonal |
| Secondary antibody type | Polymer-HRP-Goat anti-Mouse |
| Reactivity | Human, Mouse, Rat |
Kit components
| Component | Size | Concentration |
|---|---|---|
| Antigen Retrieval Buffer | 100 mL | 50× |
| Washing Buffer | 100 mL ×2 | 20× |
| Blocking Buffer | 5 mL | RTU |
| Primary Antibody | 5 mL | RTU |
| Secondary Antibody | 5 mL | RTU |
| Chromogen Component A | 0.2 mL | RTU |
| Chromogen Component B | 4 mL | RTU |
| Signal Enhancer | 5 mL | RTU |
| Counter Staining Reagent | 5 mL | RTU |
| Mounting Media | 5 mL | RTU |
| Datasheet | 1 Copy | |
| Manual | 1 Copy |
Background Information
FYN, also named as p59-Fyn and SLK, belongs to the protein kinase superfamily, Tyr protein kinase family and SRC subfamily. FYN is implicated in the control of cell growth. It plays a role in the regulation of intracellular calcium levels, with isoform 2 showing the greater ability to mobilize cytoplasmic calcium in comparison to isoform 1. FYN is required in brain development and mature brain function with important roles in the regulation of axon growth, axon guidance, and neurite extension. FYN blocks axon outgrowth and attraction induced by NTN1 by phosphorylating its receptor DDC.
Properties
| Storage Instructions | All the reagents are stored at 2-8°C. The kit is stable for 6 months from the date of receipt. |
| Synonyms | Proto-oncogene c-Fyn, Proto oncogene Syn, Proto oncogene c Fyn, p59-Fyn, p59 Fyn |